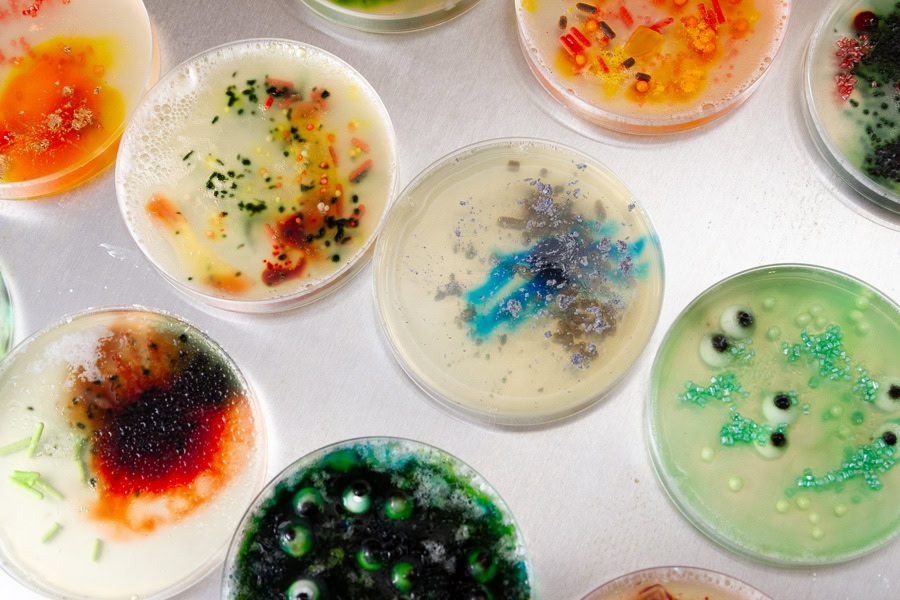
Playful candy treats arranged like colorful Petri dishes for a fun party snack.

These simple snacks look and taste like they came straight from a fancy kitchen. Each one is easy to whip up yet full of bold, irresistible flavor that keeps everyone reaching for more. Perfect for parties or cozy nights in, they make snacking feel special.
Home Made Breadsticks

These homemade breadsticks are soft, buttery, and perfectly golden, making every bite irresistible. This easy recipe fills your kitchen with the comforting aroma of freshly baked bread. Perfect for dipping in sauces, soups, or enjoying warm with butter.
Get the Recipe: Home Made Breadsticks
Pepperoni Bread

This pepperoni bread is cheesy, savory, and packed with flavor in every gooey slice. This baked loaf combines soft dough, melted cheese, and spicy pepperoni for ultimate comfort. Perfect for parties, game days, or casual family snacking anytime.
Get the Recipe: Pepperoni Bread
Easy Traeger Pigs in a Blanket

These pigs in a blanket are smoky, flaky, and full of classic backyard flavor everyone craves. This Traeger twist adds an irresistible grilled edge to the buttery pastry and sausage combo. Perfect for barbecues, tailgates, or quick crowd-pleasing appetizers.
Get the Recipe: Easy Traeger Pigs in a Blanket
Smoked Beef Bacon Jalapeno Poppers

These smoked beef bacon jalapeño poppers are spicy, smoky, and bursting with cheesy flavor. This recipe wraps jalapeños in bacon and smokes them to perfection for the ultimate bite. Great for game-day platters, backyard cookouts, or easy indulgence.
Get the Recipe: Smoked Beef Bacon Jalapeno Poppers
Pepperoni Crescent Rolls

These pepperoni crescent rolls are gooey, cheesy, and baked to golden perfection every time. This easy snack combines buttery dough with melty mozzarella and savory pepperoni. Perfect for lunchboxes, party trays, or quick after-school bites.
Get the Recipe: Pepperoni Crescent Rolls
Cinnamon Sugar Biscuit Donut Holes

These biscuit donut holes are sweet, fluffy, and coated in warm cinnamon sugar for cozy comfort. This quick treat transforms store-bought biscuits into melt-in-your-mouth bites in minutes. Perfect for breakfast, brunch, or a last-minute sweet craving.
Get the Recipe: Cinnamon Sugar Biscuit Donut Holes
Fried Mashed Potato Balls

These fried mashed potato balls are crispy, cheesy, and irresistibly creamy on the inside. This recipe turns leftover mashed potatoes into golden, snackable bites of comfort. Great for appetizers, game days, or as a creative side dish twist.
Get the Recipe: Fried Mashed Potato Balls
Chocolate Covered Oranges

These chocolate-dipped clementines are bright, zesty, and elegantly sweet in every juicy bite. This simple treat pairs citrus freshness with rich chocolate for a beautiful contrast. Perfect for gifting, snacking, or adding sparkle to dessert platters.
Get the Recipe: Chocolate Covered Oranges
Beet Chips

These beet chips are crisp, tangy, and full of earthy sweetness balanced with sea salt. This air-fried snack delivers bold flavor and crunch without the guilt of regular chips. Perfect for healthy snacking or topping your favorite sandwiches and salads.
Get the Recipe: Beet Chips
Air Fryer Mozzarella Sticks

These air fryer mozzarella sticks are golden, crispy, and filled with melty cheese bliss. This homemade version cooks up fast with all the gooey flavor and none of the grease. Perfect for movie nights, parties, or sharing with friends anytime.
Get the Recipe: Air Fryer Mozzarella Sticks
Pizza Pinwheels

These pizza pinwheels are cheesy, saucy, and baked to a perfect golden spiral every time. This fun twist on classic pizza makes an easy, handheld snack everyone loves. Perfect for lunchboxes, game-day spreads, or casual family dinners.
Get the Recipe: Pizza Pinwheels
Waffle Cookies

These waffle cookies are soft, buttery, and perfectly crisp around the edges with a hint of vanilla. This creative dessert merges breakfast fun with cookie charm in every bite. Perfect for brunch tables, afternoon coffee, or gifting with a smile.
Get the Recipe: Waffle Cookies
Air Fryer Pizza Dogs

These air fryer pizza dogs are fun, cheesy, and loaded with pepperoni flavor and melty goodness. This easy mash-up takes classic hot dogs and wraps them in pizza perfection. Perfect for kids, parties, or playful dinners that make everyone happy.
Get the Recipe: Air Fryer Pizza Dogs
Banana Muffins with Almond Flour

These banana muffins are moist, nutty, and naturally sweetened with rich banana flavor in every bite. This almond flour version makes them gluten-friendly and full of wholesome texture. Perfect for breakfast, snacks, or a quick grab-and-go treat.
Get the Recipe: Banana Muffins with Almond Flour
Easy Chocolate Mug Cake

This chocolate mug cake is rich, fudgy, and ready in just minutes with minimal effort. This single-serve dessert satisfies any late-night chocolate craving without the oven. Perfect for quick indulgence, portion control, or cozy solo treats.
Get the Recipe: Easy Chocolate Mug Cake
Banana Oat Muffins

These banana muffins are fluffy, moist, and full of that classic homemade banana aroma. This simple recipe makes soft, golden muffins that taste amazing fresh or reheated. Perfect for meal prep, breakfasts, or a warm afternoon snack.
Get the Recipe: Banana Oat Muffins
Homemade Butter Crackers

These butter crackers are crisp, flaky, and wonderfully rich with a hint of salt. This easy recipe creates snackable crackers that taste way better than store-bought ones. Perfect with cheese, dips, or as a fancy addition to charcuterie boards.
Get the Recipe: Homemade Butter Crackers
Petri Dish Treats
These petri dish treats are creative, colorful, and delightfully fun for kids and themed parties. This playful dessert combines sweet layers with a science-inspired twist for smiles all around. Perfect for birthdays, classroom snacks, or quirky get-togethers.
Get the Recipe: Petri Dish Treats
Pizza Biscuits

These pizza biscuits are soft, cheesy, and bursting with pizza flavor in a buttery, fluffy bite. This clever recipe turns biscuits into savory pull-apart mini pizzas everyone devours. Perfect for appetizers, quick snacks, or family-friendly dinners.
Get the Recipe: Pizza Biscuits
Easy Apple Spice Baked Oatmeal Bar

These baked oatmeal bars are warm, spiced, and perfectly chewy with cozy apple flavor. This make-ahead treat feels like dessert but doubles as a wholesome breakfast. Perfect for fall mornings, busy days, or afternoon snacking with tea.
Get the Recipe: Easy Apple Spice Baked Oatmeal Bar
Chinese Egg Rolls

These Chinese egg rolls are crispy, flavorful, and filled with perfectly seasoned vegetables and meat. This recipe delivers restaurant-quality crunch right from your own kitchen. Perfect as appetizers, party bites, or satisfying main meal sides.
Get the Recipe: Chinese Egg Rolls
Qingtuan(青团): Traditional Chinese Mugwort Dumplings

These qingtuan are soft, chewy, and infused with sweet, earthy mugwort flavor that’s beautifully unique. This traditional treat is filled with smooth, rich red bean paste for balance. Perfect for spring festivals, gifting, or exploring new dessert traditions.
Get the Recipe: Qingtuan(青团): Traditional Chinese Mugwort Dumplings
Candied Pecans

These candied pecans are crunchy, sweet, and coated in a rich caramelized glaze. This easy snack fills your home with a warm, toasty aroma that’s hard to resist. Perfect for holiday gifting, salads, or just sweet snacking straight from the jar.
Get the Recipe: Candied Pecans
Sweet Potato Muffins Recipe: Healthy and Fluffy

These sweet potato muffins are moist, lightly spiced, and filled with comforting fall flavor. This wholesome bake brings together natural sweetness and soft, tender texture. Perfect for cozy breakfasts, brunches, or an afternoon pick-me-up treat.
Get the Recipe: Sweet Potato Muffins Recipe: Healthy and Fluffy
